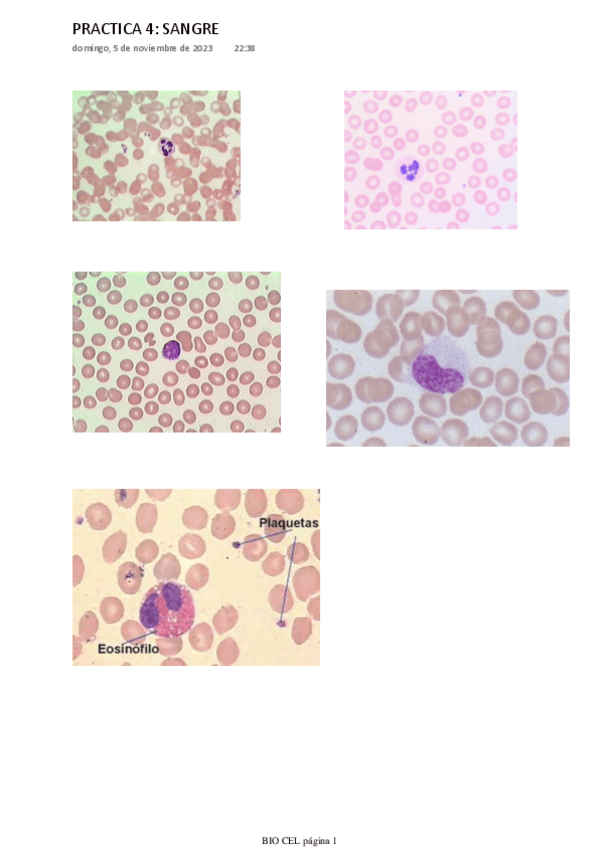

@biotuna
44 Publicaciones
80 Interacciones
6 Seguidores
0 Siguiendo
Lista de publicaciones de biotuna
apuntes
-
PRACTICAS NACHO 23-24
He publicado nuevos apuntes de 1º Biología Celular: PRACTICAS NACHO 23-24
apuntes
-
BIOCEL TEORIA NACHO 23-24
He publicado nuevos apuntes de 1º Biología Celular: BIOCEL TEORIA NACHO 23-24
He publicado nuevos ejercicios de 1º Bioquímica: Actividades-ChimeraX.pdf
apuntes
-
Seminarios 23-24
He publicado nuevos apuntes de 1º Biología Celular: Seminarios 23-24
apuntes
-
Apuntes 23-24
He publicado nuevos apuntes de 1º Biología Celular: Apuntes 23-24
apuntes
-
Seminarios 23-24
He publicado nuevos apuntes de 1º Anatomia Animal: Seminarios 23-24
apuntes
-
Teoría 23-24
He publicado nuevos apuntes de 1º Anatomia Animal: Teoría 23-24